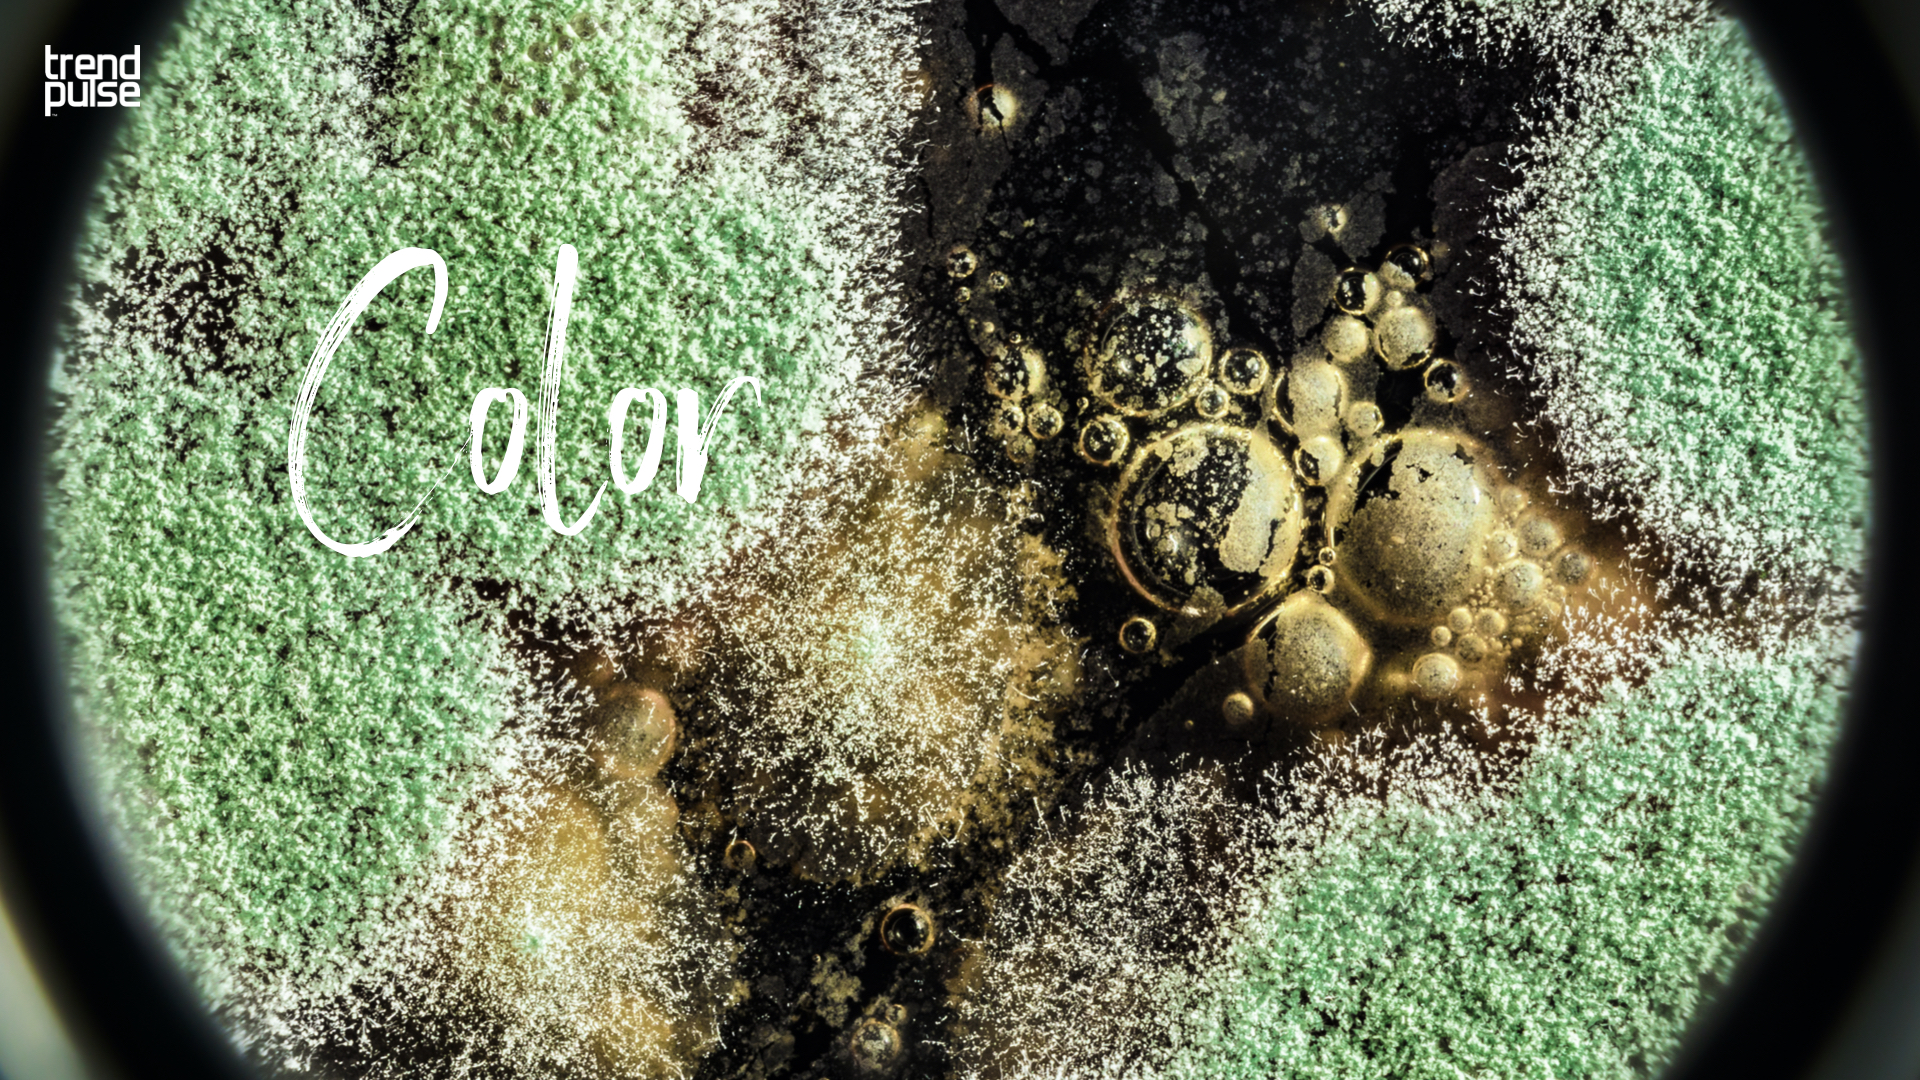

2020. 3. 20. 16:00ㆍTrendpulse/Interior

자연을 갈망하는 인간의 본성을 반영한 [ 환경의 조율 : attune environments ]
사회생물학의 아버지라고 불리는 에드워드 윌슨은 ‘자연에 대한 애정과 갈망은 인간의 본성’이라고 했다. 그는 1984년에 바이오필리아(biophillia, 생명을 뜻하는 bio와 사랑을 뜻하는 -phillia의 합성어)라는 개념을 제시하며 우리 유전자에는 생명을 사랑하는 본능이 새겨져 있다고 말했다. 목이 마르면 본능적으로 물을 찾듯이 삭막한 도시 속에서 우리는 녹색에 대한 갈증을 느끼는 것이다.
대기 오염 등의 문제로 실내에 머무는 시간이 늘어나면서 우리 내면에 존재하는 자연에 대한 갈망은 더욱 더 커지고 있다. 거주지 주변에 산이나 공원이 있길 바라는 이들이 늘어나고 있으며 공간 곳곳에 크고 작은 식물들이 자리 잡고 있다. 녹색 갈증을 해소하기 위한 우리의 본능적 움직임은 우리를 둘러싸고 있는 내・외부 환경을 조율하고 공간 속에서 또 다른 생명감을 만들어낸다.
[ STORY ]
STORY #01 - 新청산별곡


첫번째 얘깃거리는 자연 가까이 살고자 하는 현대인에 대한 스토리이다.
지난 2016년, 주택산업 연구원이 발표한 연구에 따르면, 응답자의 35프로가 주거 선택 시 가장 중요한 요인으로 ‘자연이 주는 쾌적성’을 택했다고 한다. 꾸준히 1위를 차지했던 교통 편리성을 제치고 ‘역대 최초’로 2016년에 1위가 바뀌게 된 것이다.
2016년은 미세먼지가 기승을 부리며 본격적으로 라이프스타일에 변화를 일으킨 시점이기에, 이와 같은 변화는 환경 요소가 소비자 선택에 미치는 강한 영향력을 시사하는 것으로 볼 수 있다.

이와 더불어, 최근 도심 속 대형 공원이나 산의 녹지가 미세먼지를 저감시킨다는 연구 결과들이 연이어 발표되면서 숲이나 공원이 주거 환경 가까이 위치하는 ‘숲세권’과 ‘공세권’의 선호도가 급격하게 높아졌고, 분양 시 프리미엄 옵션으로 여겨지고 있다. 집을 구할 때 확인하는 새로운 조건이 생긴 것이다.



의뢰인의 요구에 따라 집을 구해주는 MBC 예능 ‘구해줘 홈즈’에 ‘숲세권’ 주거를 원하는 의뢰인이 출현하기도 했는데, 방송에서 이들을 만족시킬 여러 숲이 등장하며, 수도권에 생각보다 숲세권이 많다는 정보를 주었다.
방송 이후 ‘숲세권’에 살고 싶다는 의견이 급증하며, 프로그램은 최고 시청률을 기록 할 만큼 큰 관심을 끌었다. ‘숲세권’이란 방송 아이템이 자연 가까이 살고자 하는 시청자들의 본성을 자극한 것이다.

사실, 모든 주거 공간이 자연과 가까우면 더할 나위 없이 좋겠지만 현실적으로는 제한적인 부분이 있기에, 건축들과 디자이너들은 사람들을 자연으로 유도하는 디자인을 하기 시작했다.
건축 스튜디오 이펙트(EFFEKT)는 나무로 빽빽히 둘러싸인 덴마크의 한 숲에 ‘캠프 어드벤쳐 타워(Camp Adventure Tower)’라는 전망대를 설치했다. 사람들은 말 그대로 ‘순수하게 자연을 전망하기’ 위한 목적으로 이 곳을 방문한다.


나무의 밑둥부터 시작하여 스파이럴 램프를 따라 꼭때기까지 관찰하며 올라가다 보면, 기가 막힌 자연의 전망이 눈 앞에 펼쳐진다. 이펙트의 공동설립자 ‘투 폴(Tue Foged)은 ‘진정한 경험을 제공하는 것은 자연이다.(Nature provides the real experience.)’ 라는 설명과 함께 이 곳에서 온전히 대자연을 느끼고 받아들이는 순간을 경험할 수 있도록 사람들을 이끌었다.

한편, 대기 오염과 같은 문제로 실내에 머무는 시간이 더 길어지면서 국내에는 자연을 내부로 끌고 들어오는 디자인이 지속적으로 증가하는 추세이다. 대부분의 소비자에게 이런 디자인은 ‘호불호(好不好)’가 아니라 ‘호호호(好好好)’로 다가간다. 그만큼 공간에서 자연이 주는 특유의 힐링은 대부분에게 통한다는 것이다.

김포에 위치한 글린공원(Gleen Park)은 ‘사람이 안정과 여유를 찾을 수 있는 곳은 자연이기에 365일 공원과 같은 여유롭고 편안한 느낌을 주고싶다.’라는 취지로 실내 공원 형식의 카페를 조성하였다. 다양한 식재와 연못으로 이루어진 조경과 인도어 캠핑, 가든과 같은 요소를 통해 자연을 접할 때 얻는 힐링을 실내에서도 충분히 경험할 수 있도록 한다.

자연을 실내에 조성하는 디자인의 정점을 찍은 공간. 지난 4월 개장한 싱가포르 창이 공항의 복합 쇼핑몰 ‘쥬얼 창이 에어포트(Jewel Changi Airport)’ 이다. 낙차 40m에 달하는 세계 최대 규모의 인공 폭포와 밀림 속 한 부분 같은 실내 정원은 안과 밖의 경계를 자연스레 허물어버린다.
오픈과 동시에 싱가포르의 필수 관광 명소로 등극할 만큼 인기를 끌고 있는 이 곳은, 자연의 스케일을 연출하여 그 경이로움을 그대로 선사한다. 하지만 그 속에 열차까지 지나다녀서 실제 자연에서는 느낄 수 없는 또 다른 느낌의 ‘신’ 자연이 만들어졌다. 청산별곡의 현대식 버전이라고 볼 수 있겠다.
STORY #02 - 녹색갈증 해소

다음은, 녹색갈증을 해소시키는 ‘바이오필릭 디자인(biophillic design)’에 대한 스토리이다.


앞서 인트로에서 언급된 바이오필리아(biophillia)의 개념에 디자인이 접목된 ‘바이오필릭 디자인(biophillic design)’은 자연을 향한 본능에 대한 이해. 그리고 그것을 바탕으로 이루어지는 디자인 행위. 즉, 친환경적 설계를 뜻한다. 앞서 첫번째 스토리에서 본 사례들이 모두 바이오필릭 디자인인 것이다.

이러한 디자인은 최근 오피스 설계에 가장 적극적으로 활용되고 있다. 공유 오피스 기업 중 하나인 세컨 홈(Second Home)은 할리우드(Hollywood)에서 가장 넓은 면적의 자연 환경을 조성한 다음, 그 안에 파드(pod) 형태의 오피스를 심어 뒀다.


숲 속 사이사이 미팅 공간과 통로가 있어 일을 하면서도 자연 속을 산책하는 것 같은 환경이다. 오피스 내에서 일할 때도 자연을 바라보게 설게 되어 있어 근무 스트레스를 완화시키고 업무 효율을 높이는 결과를 기대하게 한다.
여러 가지 식재를 통해 최대한 자연 환경을 가까이 조성하고 그 안에서 생활이 이루어지게 하는 바이오필릭 디자인을 통해, 자연을 갈망하는 우리의 녹색갈증에 대한 해갈이 이루어질 수 있을 것이다.
[ STYLE ]

앞서 본 사례들과 같이 식물을 자연으로 끌어들이는 디자인은 워낙 레퍼런스가 많고 접근도 쉬운 편이다. 그래서 이번 시즌에는 식물 활용법 이외에, 자연을 실내에서 은유적으로 표현해내는 스타일에 포커스를 맞추고자 한다.
보통 ‘자연’하면 떠오르는 이미지, 컬러에서 벗어나 그동안 눈길을 잘 주지 않았던 자연을 조명해 보고자 하는 것이다.
STYLE #01 - COLOR
상단의 이미지가 연출하는 예술 작품 같은 컬러 콤비네이션은, 현미경으로 들여다 본 곰팡이의 모습이다. 보편적으로 ‘곰팡이’라는 단어를 들을 때 부터 머릿속에 비위생적인 이미지가 형성되기 때문에 그닥 경쾌한 느낌은 아니다. 하지만 위의 이미지를 보고있자면 예상치도 못하게 형성된 자연의 아름다운 컬러에 경이로운 느낌을 받는다.

곰팡이 뿐만 아니라 ‘버섯’도 마찬가지이다. 우리의 상상 이상으로 다채롭고 아름다운 컬러와 패턴을 가지고 있다.
이처럼 ‘환경의 조율(attune environments)’에서는 그동안 주목받지 못했던 자연의 다양한 형태와 색채 같이 ‘균 종류’가 갖고 있는 의외성의 아름다움에서 영감을 받은 컬러 팔레트를 제안한다. 머쉬룸 베이지(mushroom beige), 몰드 그린 (mold green), 그리고 오묘한 청록빛을 품은 쎄룰리안 블루(Cerulean blue)가 메인 색상으로 공간에 적용된다.



이 때 컬러는 솔리드로 표현하기 보다는, 마치 물감을 물에 흘려 섞듯이 자연스럽게 확장되는 분위기로 연출한다. 이렇게 퍼져나가는 듯한 느낌의 컬러 표현은 예상할 수 없이 진행되는 비정형적 형상의 자연적 움직임을 은유적으로 담아내고 색다른 공간 연출을 가능케 한다.

환경의 조율 컬러 스킴(color scheme)이다. 깊이감이 느껴지는 톤 다운된, 블루와 그린의 베리에이션을 사용하여 전체적으로 컬러가 공간 안에서 부드럽게 흐르는 듯한 톤앤매너를 완성한다.
STYLE #02 - MATERIAL & FINISH

이어서 공간 속에 자연을 끌어들이는 중요한 요소가 되는 마감재 제안이다. 이 테마에는 그 어떤 요소보다 다채로운 자연물에 기술력이 더해져서 다양한 표현 방법을 갖게 하는 마감재가 적극적으로 활용된다.

자연 그대로의 천연대리석을 커튼 모양으로 조각한 아트월. 실제로 시공한다면 작업 방법과 그에 따르는 비용이 상상을 초월할 것이다. 하지만 다행히도(?) 위의 이미지는 대리석 조각이 아니라, 사실 인키오스트로 비앙코(Inkiostro Bianco)라는 회사의 월커버링 컬렉션이다. 과거에 비해 프린팅 기술의 아웃풋이 실사와 비슷한 수준 높은 퀄리티를 갖게되면서 소비자들이 착각을 하게끔 만들 정도이다.

다른 주제에 비해 자연을 공간에서 표현해 낼 때는, 정형적인 요소가 거의 없기 때문에 그려내기 힘든 부분이 있는데, 이때 프린팅 기술을 활용한다면 자연의 인스퍼레이션을 보다 자유롭게 공간에 적용하기 쉬워진다.


포슬린 타일(porcelain tiles) 또한 프린팅 기술의 특혜를 누리고 있는 마감재다. 앞서 컬러 제안에서 언급한 ‘자연의 퍼지는 듯한 움직임’을 공간 속에서 구체적으로 풀어내기 다소 난해할 때, 높은 퀄리티의 타일 적용으로 그 고민 해결해 볼 수 있다.



또한, 자연의 비정형적 패턴이 프린팅된 패브릭 커튼 등을 활용하여 한 쪽 면을 스케일감 있게 채워나갈 수도 있으며, 천연 소재를 엮어 만든 부드러운 텍스쳐가 살아있는 직물과 천연 염색한 패브릭 등을 활용하여 퍼져 나가는듯 한 자연의 패턴을 은유적으로 표현할 수 있다.


불투명 소재 뒤에 자연물을 배치하여 어렴풋이 보이게 하는 방법도 시도해 볼만하다. 이때 콘크리트와 같이 거칠고 단단한 재질감을 떠올리게 하는 마감재를 함께 사용하여, 자연을 살짝 품고 있는 듯한 불투명 소재의 부드러움을 더욱 부각시킨다.

자연을 그대로 레진(resin)에 굳혀 만든 마감재 또한 요즘 큰 주목을 받고 있는데, 자연물을 바라볼 때 느껴지는 순수한 즐거움을 보다 직관적으로 공간 속에서 경험할 수 있게 한다.
STYLE #03 - FURNITURE, FIXTURES, & EQUIPMENT

마지막, 가구와 소품 제안이다. 앞서 스토리 부분에서 언급된 바이오필리아(biophillia) 이론에 따르면, 우리 세포는 실제의 자연이 아닌 ‘자연적 모티브’만 본다 해도 자연을 볼 때와 같은 반응을 보인다고 한다. 인조 자연 혹은 자연을 떠올리게 하는 추상적 요소만 본다해도 우리의 세포가 반응한다는 것이다.

그렇기에 실내로 자연 환경을 끌어 들이려는 노력에 자연에서 영감을 얻은 가구와 소품이 더욱이 큰 몫을 하게 된다. 근래, 자연을 직접적 혹은 은유적으로 표현한 디자인이 눈에 띄게 늘고 있는 것도 이러한 이유에서다.


이번 시즌에는, 자연의 형태를 대놓고 ‘모사’하는 디자인, 혹은 실제 적배추 잎으로 만든 조명과 같이 (상단 이미지), 자연 소재 그 자체를 디자인 형태로 활용하여 디자인 한 제품이 눈길을 끈다.


영국의 가구업체 세바스티안 콕스(Sebastian Cox)는 버섯 균사체를 연구하여 상용화 가능한 소재로 개발하고 있다. 균사체가 만들어 내는 불규칙적인 형태와 패턴은 세상에 단 하나밖에 없는 유니크한 디자인으로 탄생되며, 동시에 자연만이 줄 수 있는 특유의 분위기를 만들어 낸다.


자연물을 이루는 형태에는 단 하나도 같은 것이 없다. 고정적이지 않고 볼 때 마다 다른 느낌을 준다. 그렇기 때문에 자연적 모티브를 공간 속에서 녹여낼 때, 그 공간이 살아움직이는 것 같은 표현이 이루어진다.


앞서 마감재 제안에서 언급했던, 생화나 드라이플라워를 그대로 합성수지에 굳혀 자연물의 순간을 영구적으로 포착한 소재는 아름다운 가구 작품으로 탄생된다. 이러한 마감재와 가구, 소품을 활용하면 자연을 끊임없이 갈망하는 이들에게 생기 있는 공간을 선사할 수 있다.

‘환경의 조율’이 완성하는 톤앤매너(tone and manner)이다. 전체적으로 딥하고 풍부한 컬러와, 번지고 확장되는 듯한 뉘앙스의 패턴이 기존과는 다른 자연을 은유적으로 표현해 내며, 바이오필릭 인테리어를 완성한다.
익숙한 공간을 새롭게 그려내는 시대의 조율(attune eras)
하나의 공간에 다양한 목적성을 담아내는 공간의 조율(attune spaces)
자연을 갈망하는 인간의 본성을 반영한 환경의 조율(attune environments)
이번 시즌은 위의 세 테마가 만들어지게 된 각각의 스토리 (공간 변화 트렌드)를 바탕으로 그 변화의 흐름에 어울리는 공간 CMF를 제안하였다. 앞서 INTRO 포스팅에서 언급한 바와 같이, 각 공간에 담긴 스토리는 독자(소비자)의 취향에 의해 선택되고 걸러지는 작업을 통해 각자만의 스타일로 완성될 것이다. 다음 시즌에는 또 어떤 변화들이 만들어지고 공유될지 기대해보며, 이번 포스팅을 마지막으로 KCC TrendPulse 2020의 인테리어 트렌드 제안을 마친다.
- the end -
※ 무단 전재 및 재배포 금지 I Copy or reproduction of this material is strictly prohibited by the copyright law.
COPYRIGHT © 2020 KCC CORPORATION. ALL RIGHTS RESERVED
'Trendpulse > Interior' 카테고리의 다른 글
| 2021 Trendpulse. CMF 트렌드 프롤로그_CMF Trend Prologue (0) | 2021.05.31 |
|---|---|
| 2021 인테리어 트렌드_ 1 LAYERED (0) | 2021.04.12 |
| 2020 인테리어 트렌드_2 공간의 조율 (0) | 2020.03.19 |
| 2020 인테리어 트렌드_1 시대의 조율 (0) | 2020.03.17 |
| 2020 인테리어 트렌드_INTRO (0) | 2020.03.16 |